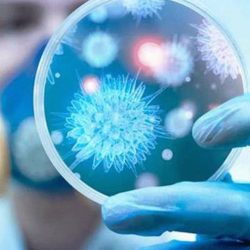
“السعودية للكهرباء”: تركيب العدادات الذكية يسير وفق الخطط الموضوعة

أكدت الشركة السعودية للكهرباء، أن مشروع تركيب العدادات الذكية يسير وفق الخطط الموضوعة، وبدون أي تكاليف على المشتركين. وأوضحت الشركة أن رحلة المشترك لتركيب العداد الذكي، تمر بثلاث مراحل؛ الأولى تتمثل في استبدال العداد الحالي بالعداد الذكي، يلي ذلك ربط أنظمة الاتصالات، وصولاً إلى المرحلة الأخيرة بربط أنظمة الفوترة وإتاحتها على تطبيق الكهرباء للأجهزة الذكية.
وأشارت “السعودية للكهرباء” إلى أن العدادات الذكية، هي مشروعها الأهم نحو التحول الرقمي، ومحور استراتيجيتها الهادفة للارتقاء بمستوى الخدمات إلى الأفضل، كما أنها المشروع الواعد نحو تنمية وطنية شاملة تقودها رؤية المملكة 2030، إلى مستقبل زاهر. ويشمل المشروع تركيب 10 ملايين عداد ذكي في جميع مدن ومحافظات وقرى وهجر المملكة، وينتهي في نهاية مارس 2021، على أن تكون 35% منها كحد أدنى، تدعم المحتوى المحلي (إنتاج سعودي).
وقالت الشركة: “إنه بعد اكتمال جميع مراحل المشروع، ستتيح العدادات الذكية مجموعة من المميزات التي تسهم في تحسين خدمات الكهرباء في المملكة، حيث تقدم منظومة آلية من القراءة وحتى الفوترة، دون أي تدخل بشري في إدخال القراءات أو آليات الفوترة، كما تتيح مراقبة الاستهلاك بشكل لحظي من خلال تطبيقات الأجهزة الذكية، والحصول على معلومات تفصيلية لاستهلاك الكهرباء بما يساعد المشترك على تعديل النمط الاستهلاكي”. وبينت أن العدادات الذكية تتيح إعادة الخدمة عن بعد في فترة زمنية قصيرة، بدلاً من الإعادة الذاتية التي قد تستغرق وقتًا أطول، كما أنها تسهم في رفع موثوقية الشبكة الكهربائية، وتقليص مدة الانقطاعات، مع تقنيات اتصال حديثة لتبادل البيانات، وتدعم خاصية الدفع المسبق في حال تم إقرار تفعيلها، وتقنيات قراءة سريعة وآنية للبيانات من موقع العداد، وتقنيات تدعم خدمة “حسابي” لتحويل الخدمة آلياً نحو المستفيد النهائي من الكهرباء (Move In – Move out)، سواء كان مالكًا أو مستأجراً.
وأفادت الشركة أن من مميزات هذه العدادات أيضاً، أنها تملك قدرة عالية على تحمل الظروف المناخية (+75/ – 10)، وحماية عالية من آثار الرطوبة والأمطار والغبار، كما أنها تضم تقنيات متطورة لقياس جودة الطاقة، مع مرونة بسعات تتناسب مع الأحمال ونمط الاستهلاك في المملكة، وأيضاً مرونة وجودة عالية تقبل التقنيات الجديدة مستقبلاً.
وشددت “السعودية للكهرباء” على أن الشركة ستعمل على إشعار المشتركين بتركيب العداد الذكي عبر رسالة نصية قبل الموعد المحدد، كما ستتواصل معهم لاطلاعهم على سير المشروع أولاً بأول، وأملت من المشتركين تحديث بيانات حساباتهم وربطها برقم الجوال من خلال منصة “حسابي”.